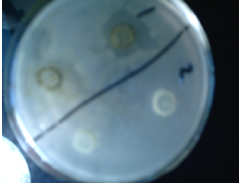
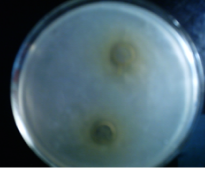
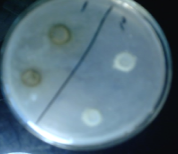

Int J Pharm Pharm Sci, Vol 15, Issue 10, 34-39Original Article
ANTIMICROBIAL AND PHYTOCHEMICAL INVESTIGATION OF CALOTOROPIS PROCERA FLOWERS EXTRACTS
SARA HUSSEIN ALTAYEB1*, ASAAD KHALID2,3
1Department of Chemistry, College of Science, Jazan University. Jazan-45142. P. O Box No. 114, KSA. 2Substance Abuse and Toxicology Research Centre, Jazan University, Jazan-45142, P. O. Box 114, Saudi Arabia. 3Medicinal and Aromatic Plants and Traditional Medicine Research Institute, National Center for Research, P. O. Box: 2424, Khartoum-11111, Sudan
*Corresponding author: Sara Hussein Altayeb; *Email: saltayeb@jazanu.edu.sa
Received: 20 May 2023, Revised and Accepted: 05 Aug 2023
ABSTRAC
Objective: The present study was planned to screen extracts of different polarities of the flowers of Calotropis procera for the detection of different secondary metabolites, estimate the antibacterial activity of the prepared extracts, and study the active extracts by different chromatographic and spectroscopic methods.
Methods: The diethyl ether, methanol, and water extracts were phytochemically screened. Petroleum ether, chloroform, and methanol extracts were also tested against two Gram-positive bacteria, namely Bacillus subtilis and Staphylococcus aureus, and two Gram-negative bacteria, namely E. coli and Pseudomonas aeruginosa with diffusion method. The methanolic extract was further investigated by column chromatography (CC) and preparative thin-layer chromatography (PTLC). Three pure compounds have been isolated and investigated by IR-spectroscopy.
Results: Phytochemical screen showed the presence of various secondary metabolites such as flavonoids, alkaloids, steroids, cardiac glycosides, reducing sugars, and saponins. The antibacterial assay revealed that the methanolic extract was the most active against the tested bacteria, especially against Pseudomonas aeruginosa with the high zone of inhibition (23 mm) at 100 mg/ml, and E. coli (22 mm) at 100 mg/ml, followed by chloroform extract, while the petroleum ether extract was insignificantly active. Column Chromatography analysis of the methanolic extract separated fifteen fractions. The PTLC of fraction No.14 enabled the isolation of three pure compounds (A, B, and C). The IR-spectroscopy analysis of the three isolated compounds exhibited that they could referred to the alkaloids or cardiac glycosides.
Conclusion: The methanolic extract showed significant activity against tested bacteria, especially E. coli and Pseudomonas aeruginosa. The result also indicates the presence of secondary metabolites in C. procera extracts. Subsequently the therapeutic efficacy compounds isolated and purified from C. procera could be used as an important source against bacterial ailments in humans and plants.
Keywords: Calotropis procera, Anti-microbial, Phytochemical
© 2023 The Authors. Published by Innovare Academic Sciences Pvt Ltd. This is an open access article under the CC BY license (https://creativecommons.org/licenses/by/4.0/)
DOI: https://dx.doi.org/10.22159/ijpps.2023v15i10.48379. Journal homepage: https://innovareacademics.in/journals/index.php/ijpps.
INTRODUCTION
Throughout history, plants have played a substantial role in medicine. For early peoples, they came easily to hand and were complicatedly connected to diet and healing. Plants are a valuable source of new natural products. Despite the availability of different approaches for the discovery of therapeutics, natural products remain one of the best reservoirs of new structural types [1].
The present study is concerned with Calotropis procera. Its common name in Sudan is Ushar. It belongs to the family Asclepiadaceae with 180 genera and 2200 species widespread in tropical and subtropical regions of the world such as Africa (Mauritania, Singal), Asia (India, Bangladesh), Australia, and America [2]. This plant used as a medicinal plant: In Southern Blue Nile in Sudan, the fresh flowers are eaten as a digestive [3]. The Milky latex used in leprosy, eczema, inflammation, syphilis, malarial and low hectic fevers, and as an abortifacient. The leaves: in rheumatism, as anti-inflammatory and antimicrobial. The roots: as hepatoprotective agents, against colds and coughs, syphilis, and elephantiasis, as an anti-inflammatory, analgesic, antimalarial, and antimicrobial. Flowers: as abortifacient, antimalarial, in asthma and piles [4]. In Nigeria, leaves are used for the treatment of guinea worm [5].
Calotropis is a large shrub or small tree up to 4-10 m, stem erect up to 20 cm in diameter, bark pale gray, latex in all parts. It’s flowers are bisexual, regular, 5-numerous, white, cream or purple, with green spongy ovoid fruits which split open to release light brown seed with a white filament [6] (fig. 1a fig. 1b).


(a) (b)
Fig. 1: Calotropis procera shurb (a), Flowers of C. procera (b)
Studies about the toxicity of C. procera revealed that the latex and the crude extracts had a toxic effect against Black Rats and Rattus, Termites, and Goat [7-9]. Also, the extract of leaves of C. procera exhibited insecticidal activity against flesh fly, Sarcophaga haemorrhoidalis fallen [10]. In the wet season of Northern Australia, the plant was not toxic in the same doses that caused acute poisoning elsewhere, so it was assumed that either the toxin was not present in the northern Australia species or that local conditions did not enhance the production of the toxin [11].
Calotropis procera has shown cytotoxic activity [12], and the crud extract produced by the isolated endophytic fungus from its root could be an important source of broad-spectrum antimicrobial metabolites [13].
This study was designed to determine the phytochemicals present in different polarities solvent extracts of the flowers of C. procera and to evaluate the antimicrobial activity of C. procera extracts.
MATERIALS AND METHODS
Plant material
The flowers of Calotropis procera were collected from the Blue Nile bank in Khartoum, Sudan. The plant was identified at the Medicinal and Aromatic Plants Research Institute, National Center for Research in Khartoum, Sudan, with specimen number (SD-SH-11), by the researcher Yahia Suliman.
Chemicals and reagents
Chloroform, diethyl ether, distilled water, ethanol 96%, ethyl acetate, methanol, and petroleum ether. Ansildehyde’s reagent, Dragendroff’s reagent, Kedde’s reagent, Molisch’s reagent, Mayer’s reagent, Fehling’s solution, FeCl3 10%, KOH (alcoholic 25%), SbCl3 20%, HCl, acetic anhydride, ammonia 25%, sulphuric acid, and vinlline were used for phytochemical screening. Silica gel GLR for PTLC, silica gel 230-400 mesh were used for column chromatography.
Plant extract preparation
Air-dried and powdered flowers of Calotropis procera 300 g were extracted using Soxhlet apparatus at room temperature using three different solvents: petroleum ether, chloroform, and methanol. In a rotary evaporator the extracts were concentrated, then the yields were determined. The extracts were labeled and kept in a refrigerator at 4 ᵒC for further study.
Phytochemical screening qualitative analysis
To achieve this analysis, 20 g of powdered flowers were extracted with diethyl ether for 4 h at 30 ᵒC using a Soxhlet apparatus, and the extract was concentrated up to 50 ml, and was used for the identification of lipophilic constituents. The marc was dried and then extracted with methanol for 2 h at 60 ᵒC, the extract was concentrated up to 50 ml, and used for identification of an important groups of natural constituents. The marc was dried and extracted with distilled water in conical flask for 24 h, the filtrate solution was concentrated up to 50 ml and used for identification of hydrophilic constituents. The preliminary phytochemicals {fatty substances, sterols, triterpenes, higher fatty acids, alkaloids, flavonoids, anthracene glycosides, coumarins, tannins, reducing compounds, cardiac glycosides/cardenolides/bufadienolides, anthocyanosides, polyuronides, glucides, starch, and saponins} screening at different solvent extracts, were carried out using standard a method as described by Harbone [14].
Chromatographic analysis
The methanolic extract that exhibited significant activity against the selected bacteria was analyzed by column chromatography using silica gel 230-400 mesh and eluted with petroleum ether, ethyl acetate, methanol, and, at last, distilled water. Fraction No.14 was selected and subjected to PTLC to separate pure constituents by utilizing a thick layer of adsorbent silica gel 0.5 mm on glass plates (5×20) cm and (20×20) cm, solvent system: toluene–ethyl acetate–formic acid (5:4:1), and vanillin-sulphuric acid reagent for detection.
Screening of antimicrobial activity
Four kinds of bacteria were used for the antibacterial test: Escherichia Coli (ATCC 25922), Bacillus subtilis (NCTC 8236), Pseudomonas aeruginosa (ATCC 27853), and Staphylococcus aureus (ATCC 25923). The standard organisms were obtained from the National Collection of Type Culture (NCTC), Colindale, England and the American Type Culture Collection (ATCC), Rockville, Maryland, USA. For tests, they were obtained from the Microbiology Department of The National Research Center, and the National Health Laboratory, Sudan.
Antibacterial activity of different solvent extracts of C. procera was investigated against two Gram-positive bacteria, Bacillus subtilis and Staphylococcus aureus, and two Gram-negative organisms, Escherichia coli and Pseudomonas aeruginosa, by well diffusion method that adopted with some minor modifications [15]. The obtained cultures were maintained on nutrient agar and incubated at 37 °C for 18 h and then used for tests. 2 ml of the standardized bacterial stock suspension (108-109) colony-forming units, per ml were thoroughly mixed with about 200 ml of sterile nutrient agar, which was maintained at 45 °C. 20 ml aliquots of the inoculated agar were distributed into sterile Petri dishes. The agar was left to set and cool, then in each of these plates, 4 cups ( in diameter) were cut using a sterile cork borer No 4, while in 4 plates, only 2 cups in the medial of the plates were cut using sterile cork. The agar discs were removed. The cups were then filled with 0.1 ml sample of each extract using an adjustable micropipette and allowed to diffuse at room temperature for about 2 h. The plates were then incubated in the upright position at 37 °C for 18 h. Three replicates were carried out for each extract against each of the tested organisms. Positive control involving the addition of standard antibiotics were carried out, and dimethyl sulphoroxide (DMSO) as the negative control. Diameters of the resultant growth inhibition zone were measured in mm.
RESULTS AND DISCUSSION
Exhaustive extraction of the Calotropis procera flowers was performed in a Soxhlet apparatus with solvents increasing in polarity. The percentage yield and the physical properties were summarized in (table 1).
Table 1: Percentage yield and physical properties of C. procera flowers
| Extract | Percentage yield | Physical properties |
| Petroleum ether | 1.29 %±0.00 | Waxy yellow |
| Chloroform | 1.039%±0.00 | Waxy dark green |
| Methanol | 21.20 %±0.00 | Sticky brown |
Number of experiments: 3,‘±’SD
Phytochemical screening of the flowers of Calotropis procera
Results of general phytochemical screening of diethyl ether, methanol, and water extracts of the flowers of Calotropis procera were presented in (table 2, table 3, and table 4) respectively. Qualitative analysis of the flowers extracts revealed the presence of alkaloids, flavonoids, carotenoids, sterols/triterpenes, higher fatty acids, coumarins, tannins, reducing compounds, cardiac glycosides, polyuronides, glucides, and saponins. The previous study on the aerial parts of C. procera also supported the presence of different phytochemicals such as alkaloids, cardiac glycosides, tannins, flavonoids, sterols, and triterpenes [16].
Table 2: Qualitative analysis of diethyl ether extract of C. procera flowers
| Test for | Result |
| Sterols and Triterpenes | + |
| Carotenoids | + |
| Higher fatty acids | + |
| Basic alkaloids | - |
| Flavonoids | + |
| Anthracen-glycosides | - |
| Coumarins | + |
‘+’-Present, ‘-’-Absent
Table 3: Qualitative analysis of methanol extract of C. procera flowers
| Test for | Result |
| Tannins | + |
| Reducing reagent compounds | + |
| Alkaloids | + |
| Anthracene-glycosides | - |
| Sterols and triterpenes | + |
| Coumarins | + |
| Flavonoids | + |
Cardiac glycosides:- Kedde test Liebermann test Antimony trichloride |
+ |
| + | |
| + |
‘+’-Present, ‘-’-Absent
Table 4: Qualitative analysis of aqueous extract of C. procera flowers
| Test for | Result |
| Polyuronides | + |
| Reducing reagent compounds | + |
| Glucides | + |
| Starch | - |
| Saponins | + |
| Tannins | + |
| Alkaloid salts | - |
‘+’-Present, ‘-’-Absent
Antibacterial activity of extracts of C. procera flowers
The extracts of petroleum ether, chloroform, and methanol (100 mg/ml), were tested against four kinds of bacteria: Escherichia Coli, Bacillus subtilis, Pseudomonas aeruginosa, and Staphylococcus aureus. The inhibition zones (mm) were shown in (table 5). The methanolic extract exhibited antibacterial activity against both (G-positive) and (G-negative) bacteria. Significant activity was observed against pseudomonas aeruginosa and E. coli (G-negative). On the other hand, the petroleum ether and chloroform extracts showed insignificant activity against the tested bacteria (fig. 2, fig. 3). Various active components present in C. procera extract like alkaloids, tannins, saponins, terpenoids, glycosides, and flavonoids, are secondary metabolites which serve a protective mechanism against many microorganisms [17]. A previous study has shown that flavonoids have been identified as polyphenolic compounds capable of exerting antibacterial activities via various mechanisms of action [18]. Similarly, Larhsini M et al. reported the potent antibacterial activity of the n-butanol extract of Calotropis procera flowers against eight pathogenic bacteria [19]. Another study revealed that the flower extracts of C. procera have the potential to be used as an antibacterial agent against pathogenic organisms like Salmonella typhi, Escherichia coli, Micrococcus luteus, and methicillin-resistant Staphylococcus aureus [20].
The number and physical properties of fractions obtained from the methanol extract by column chromatography were presented in (table 6).

Fig. 2: Antibacterial activity of the extracts of C. procera flowers against E. coli

Fig. 3: Antibacterial activity of the extracts of C. procera flowers against Staphylococcus aureus
Table 5: Antibacterial screening of the extracts of C. porcera flowers
| Extracts | Inhibition zone (mm) | |||
| Organism | ||||
| S. A | Ps. a | B. a | E. coli | |
| Petroleum ether | - | 12±0.05 | - | - |
| Chloroform | - | 14±0.05 | 13±0.11 | 06±0.05 |
| Methanol | 15±0.10 | 23±0.25 | 18±0.15 | 22±0.10 |
Number of experiments (ne):3, ‘±’Standard Deviation, ‘-’-Absent
Table 6: Numbers of fractions and colours of fractions obtained from column chromatography
| Number of fraction | Colour |
| 1 | Colourless |
| 2 | Colourless |
| 3 | Yellow |
| 4 | Yellow |
| 5 | Yellow |
| 6 | Green |
| 7 | Green |
| 8 | Colourless |
| 9 | Colourless |
| 10 | Yellow |
| 11 | Brown |
| 12 | Brown |
| 13 | Brown |
| 14 | Brown |
| *15 | Brown |
Solvents of elution: -petroleum ether, ethyl acetate, methanol and distilled water. *Fraction No. 15 contained a crystalline compound with melting point = 150-160 °C
Isolation of three pure constituents of C. procera flowers
Fraction No. 14 was further selected for the separation of compounds by PTLC and ended up with the isolation of three pure compounds. The three compounds (A, B, and C) were examined by IR-spectroscopy (Thermo Nicolet Mattson 300IR) to determine their functional groups in an attempt to spot more light on their structure (fig. 4, fig. 5, fig. 6) respectively. Comparing the type of vibration, frequency, and intensity of IR-spectra of compounds A, B, and C with data available in the literature, one could conclude that the three compounds were from one class, either Cardenolides or Nitrogenous compounds. Both types were detected in the extracts of the flowers and confirmed upon comparison with published data in the current literature.
Table 7: Assignments of IR-spectrum of compound A
| Peak (cm-1) | Bond | Type of compound | Intensity |
| 3850.14 | |||
| 3442.19 | O-H N-H |
Monomeric alcohols, phenols, hydrogen-bonded alcohols, phenol, amine, amide | 67.860 |
| 2923.97 | C-H | Alkanes | 63.108 |
| 2852.90 | C-H | Alkanes | 67.818 |
| 2358.86 | CΞ N | Nitriles | 76.144 |
| 1728.94 | C= O | Aldehydes, ketones, carboxylic acid, ester | 75.093 |
| 1600.78 | C=C | Aromatic ring | |
| 1463.04 | C-H | Alkanes | |
| 1383.32 | C-H | Alkanes | |
| 1276.27 | C-N | Amine,amide | |
| 1036.19 | C-O | Alcohols, ether, carboxylic acids, esters | 74.020 |

Fig. 4: IR-spectrum of compound A
Table 8: Assignments of IR-spectrum of compound B
| Peak (cm-1) | Bond | Type of compound | Intensity |
| 3901.42 | |||
| 3734.02 | |||
| 3565.79 | O-H N-H |
Monomeric alcohols, phenols, hydrogen-bonded alcohols, phenol. Amine, amide | 65.182 |
| 3445.23 | O-H N-H |
Monomeric alcohols, phenols, hydrogen-bonded alcohols, phenol, Amine amide | 64.114 |
| 2924.08 | C-H | Alkanes | 62.548 |
| 2853.20 | C-H | Alkanes | 65.032 |
| 2360.19 | CΞ N | Nitriles | 61.946 |
| 2341.29 | CΞ N | // | 64.039 |
| 1747.09 | C= O | Aldehydes, ketones, carboxylic acids, esters. | |
| 1616.96 | C=C | Aromatic ring | |
| 1456.76 | C-H | Alkanes | |
| 1396.47 | C-H | // | |
| 1031.74 | C-O | alcohols, ether, carboxylic acids, esters |

Fig. 5: IR-spectrum of compound B
Table 9: Assignments of IR-spectrum of compound C
| Peak (cm-1) | Bond | Type of compound | Intensity |
| 3735.96 | 74.980 | ||
| 3461.70 | O-H N-H |
Monomeric alcohols, phenols, hydrogen-bonded alcohols, phenol, amine, amide | |
| 2924.43 | C-H | Alkanes | 69.786 |
| 2853.49 | C-H | Alkanes | 72.65 |
| 2360.29 | CΞ N | Nitriles | 71.996 |
| 2341.37 | CΞ N | Nitriles | 73.310 |
| 1734.40 | C=O | Aldehydes, ketones, carboxylic acid, esters | 76.434 |
| 1619.16 | C=C | Aromatic ring | |
| 1458.87 | C-H | alkanes | |
| 1383.44 | C-H | // | |
| 1273.74 | C-N | Amines,amides | |
| 1219.47 | C-N | // | |
| 1037.57 | C-O | alcohols, ether, carboxylic acids, esters |

Fig. 6: IR-spectrum of compound C
CONCLUSION
The phytochemical screen of the extracts of flowers of C. procera revealed the presence of secondary metabolites, namely alkaloids, flavonoids, fatty acids, sterols/triterpenes, cardiac glycosides, coumarins, saponins, tannins, reducing sugars and polyuronides. The analysis of antimicrobial activity showed that the petroleum ether and chloroform extracts had insignificant activity against the tested bacteria, while the methanolic extract was significantly active, there for the methanolic extract was selected for more detailed studies using different chromatographic methods such as CC, and PTLC. Three pure compounds designated as A, B, and C have been isolated in a pure form and studied by IR-spectroscopy to spot more light on their structures. Interpretation of results could give grounds to suggest that the compounds were probably alkaloids or cardiac glycosides. further investigation into this plant could be more valuable in the availability of advanced technology.
ACKNOWLEDGEMENT
The authors appreciate the support of the National Center for Research, Sudan, and the Department of Chemistry, Jazan University, Saudi Arabia.
FUNDING
Nil
AUTHORS CONTRIBUTIONS
Sara H. Altayeb performed the experiments and edited the document, Asaad Kh. designed and edited the document. Both authors have read and approved the final manuscript of this article.
CONFLICTS OF INTERESTS
Declared none
REFERENCES
-
Hostettmann K. Strategy for the biological and chemical evaluation of plant extracts. Pure Appl Chem. 1999;70(11):1-9.
-
Ravi K. A review of ethnomedicinal, pharmaceutical and pesticidal uses of Calotropis procera (Aiton) (family: Asclepiadaceae). Int J Green Pharm. 2014;8(3):135-46.
-
El-Kamali HH, El-Khalifa KF. Folk medicinal plants of riverside forests of the Southern Blue Nile District, Sudan. Fitoterapia. 1999;70(5):493-7. doi: 10.1016/S0367-326X(99)00073-8.
-
Sharma P, Sharma JD. In vitro schizonticidal screening of calotropis procera. Fitoterapia. 2000;71(1):77-9. doi: 10.1016/S0367-326X(99)00121-5.
-
Fabiyi JP, Kela SL, Tal KM, Istifanus WA. Traditional therapy of dracunculiasis in the state of Bauchi–Nigeria. Dakar Med. 1993;38(2):193-5. PMID 7758381.
-
Shamim SA, Lubna F. A review of pharmacological actions and therapeutic uses of Ask Calotropis procera. J Pharm Innov J 2019;8(2):40-7.
-
Rahaw R, Chatterjee V. The toxicity of Indian C. procera RBr latex in the black rattus Linn. Vet H. Toxicol 1988;30(4):305-8.
-
HB, F ZS, AS, MS. Toxic effects of Ak (Calotrpis procera) plant extracts against termites (Heterotermes indicola and coptotermes heimi) isoptera: rhinotermitidae. Pak J Biol Sci. 2004;7(9):1603-6. doi: 10.3923/pjbs.2004.1603.1606.
-
Moursy LE. Insecticidal activity of Calotropis procera extracts of the flesh fly, sarcophaga haemorrhoidalis fallen. J Egypt Soc Parasitol. 1997;27(2):505-14. PMID 9257990.
-
Radunz BL, Wilson G, Beere G. Feeding rubberbush (Calotropis procera) to cattle and sheep. Aust Vet J. 1984;61(7):243-4. doi: 10.1111/j.1751-0813.1984.tb06006.x, PMID 6497815.
-
Suraj S, Padma Ch. Brain shrimp cytotoxic activity of 50% aqueous ethanolic leaf extract of Calotropis procera R. Br. Asian J Pharm Clin Res. 2015;8(6):215-7.
-
Shivkr V, Motilal MD. Optimization of process parameter for production of antimicrobial metabolites by endophytic fungus Aspergillus sp. CPR5 isolated from Calotropis procera root. Asian J Pharm Clin Res. 2017;10(4):225-30.
-
Harbone JB. Phytochemical method, a guide to modern technique of plants. 3rd ed. 1998;302:0412-57260-5.
-
Kavanagh F. Analytical microbiology. Academic press; 1972. p. 2.
-
Mossa JS, Tariq M, Mohsin A, Ageel AM, Al-Yahya MA, Al-Said MS. Pharmacological Studies on aerial parts of Calotropis procera. Am J Chin Med. 1991;19(3-4):223-31. doi: 10.1142/S0192415X91000302, PMID 1767794.
-
Sharma H, Garg M. A review of traditional use, phytoconstituents and biological activities of Himalayan yew, Taxus wallichiana. J Integr Med. 2015;13(2):80-90. doi: 10.1016/S2095-4964(15)60161-3, PMID 25797638.
-
Shamsudin NF, Ahmed QU, Mahmood S, Ali Shah SA, Khatib A, Mukhtar S. Antibacterial effects of flavonoids and their structure-activity relationship study: a comparative interpretation. Molecules. 2022;27(4):1149. doi: 10.3390/molecules27041149, PMID 35208939.
-
Larhsini M, Oumoulid L, Lazrek HB, Wataleb S, Bousaid M, Bekkouche K. Antibacterial activity of some moroccan medicinal plants. Phytother Res. 2001;15(3):250-2. doi: 10.1002/ptr.815, PMID 11351362.
-
Abid A, Asma A, Shah Ali U, Majid M, Sumayya S, Tabassum M. Antibacterial potential of Calotropis procera (flower) extract against various pathogens. Pak J Pharm Sci. 2014;27(5):1565-9.